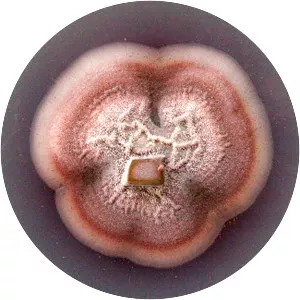
Clonostachys rosea f. rosea

Hypocreales
The Hypocreales are an order of fungi within the class Sordariomycetes. In 2008, it was estimated that it contained some 237 genera, and 2647 species in seven families. Since then, a considerable number of further taxa have been identified, including an additional family, the Stachybotryaceae.